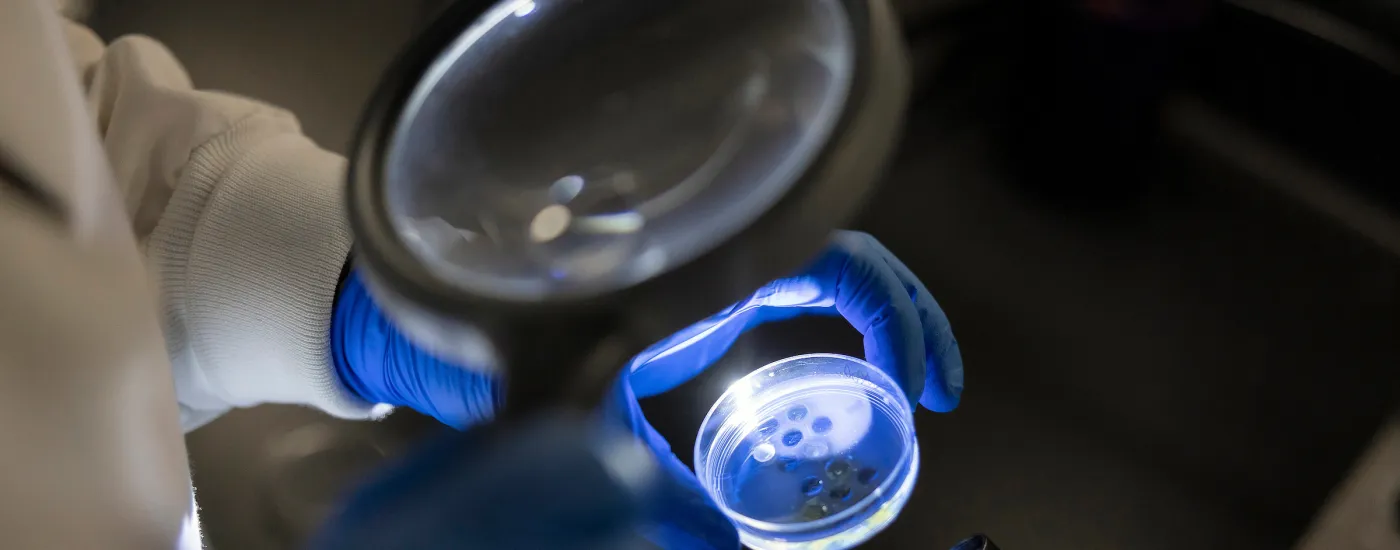
Researcher looking through a magnifying glass at a culture.

Travel Award Winners
This page highlights recipients of CURE-KY Travel Awards, which support early faculty and trainees in presenting their infectious disease research at national and international conferences. These awards help promote professional development, foster collaboration, and broaden the visibility of CURE-KY research within the global scientific community. We are proud to showcase the achievements of our travel awardees.
| Name | College | Conference | Conference Location | Dates |
|---|---|---|---|---|
| Caroline Hawk | Medicine | Biennial Meeting for the Chlamydia Basic Research Society (CBRS) | Berlin, Germany | March 23-27, 2025 |
| Gracie Eicher | Medicine | Biennial Meeting for the Chlamydia Basic Research Society (CBRS) | Berlin, Germany | March 23-27, 2025 |
| Chase Heim | Medicine | International RSV Symposium | Iguazu Falls, Brazil | March 12-15, 2025 |
| Hami Hemati | Medicine | Alcohol-Induced End Organ Diseases Gordon Research Conference | Ventura, CA | March 16-21, 2025 |
| Madison Blanton | Medicine | Alcohol-Induced End Organ Diseases Gordon Research Conference | Ventura, CA | March 16-21, 2025 |
| Hunter Curry | Pharmacy | European Congress of Clinical Microbiology and Infectious Diseases | Vienna, Austria | April 11-15, 2025 |
| Nicole Slain | Pharmacy | European Congress of Clinical Microbiology and Infectious Diseases | Vienna, Austria | April 11-15, 2025 |
| Heather True | Pharmacy | American Society for Reproductive Immunology | St. Paul, MN | May 17-21, 2025 |
| Qian Wang | Medicine | 48th Shock Society Conference | Boston, MA | May 31 - June 3, 2025 |
| Jimmy Xue | Medicine | 48th Shock Society Conference | Boston, MA | May 31 - June 3, 2025 |
| Katherine Olney | Pharmacy | Society of Infectious Diseases Pharmacists (SIDP) Pharmacokinetic/Pharmacodynamic (PK/PD) Conference | Madison, WI | June 2, 2025 |
| Ajran Kabir | Agriculture, Food and Environment | International Association for Food Protection (IAFP), 2025 Annual Meeting | Cleveland, OH | July 27-30, 2025 |
| Bibek Lamichhane | Agriculture, Food and Environment | International Association for Food Protection (IAFP), 2025 Annual Meeting | Cleveland, OH | July 27-30, 2025 |
| Maisha Rahman | Public Health | Infectious Diseases Society of America’s ID Week | Atlanta, GA | October 19-22, 2025 |
| Elizabeth May | Pharmacy | Infectious Diseases Society of America’s ID Week | Atlanta, GA | October 19-22, 2025 |
| Kenneth Schlabach | Pharmacy | Infectious Diseases Society of America’s ID Week | Atlanta, GA | October 19-22, 2025 |